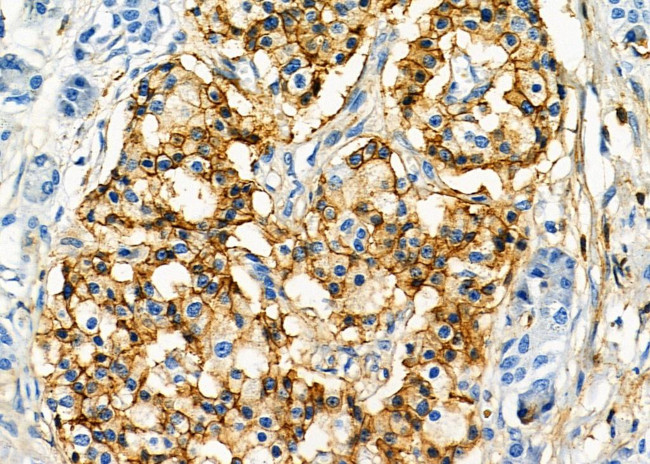
KIR2DL5A Antibody in Immunohistochemistry (Paraffin) (IHC (P))

Search
Invitrogen
KIR2DL5A Polyclonal Antibody
{{$productOrderCtrl.translations['antibody.pdp.commerceCard.promotion.promotions']}}
{{$productOrderCtrl.translations['antibody.pdp.commerceCard.promotion.viewpromo']}}
{{$productOrderCtrl.translations['antibody.pdp.commerceCard.promotion.promocode']}}: {{promo.promoCode}} {{promo.promoTitle}} {{promo.promoDescription}}. {{$productOrderCtrl.translations['antibody.pdp.commerceCard.promotion.learnmore']}}
图: 1 / 6
KIR2DL5A Antibody (PA5-103909) in IHC (P)






Please note: We are reviewing Western blot images included in the antibody testing data in our catalog, including those provided by third parties. Unless expressly labeled or annotated as “raw-unedited”, Western blot images included in the antibody testing data in our catalog may have been edited, optimized or otherwise adjusted for presentation.
产品信息
PA5-103909
种属反应
宿主/亚型
分类
类型
抗原
偶联物
形式
浓度
规格
纯化类型
保存液
内含物
保存条件
运输条件
RRID
产品详细信息
Antibody detects endogenous levels of total KIR2DL5A.
靶标信息
KIR2DL5A and KIR2DL5B are Killer cell immunoglobulin-like receptors (KIRs), transmembrane glycoproteins expressed by natural killer cells and subsets of T cells. The KIR genes are polymorphic and highly homologous and they are found in a cluster on chromosome 19q13.4 within the 1 Mb leukocyte receptor complex (LRC). The gene content of the KIR gene cluster varies among haplotypes, although several "framework" genes are found in all haplotypes. The KIR proteins are classified by the number of extracellular immunoglobulin domains (2D or 3D) and by whether they have a long (L) or short (S) cytoplasmic domain. KIR proteins with the long cytoplasmic domain transduce inhibitory signals upon ligand binding via an immune tyrosine-based inhibitory motif (ITIM), while KIR proteins with the short cytoplasmic domain lack the ITIM motif and instead associate with the TYRO protein tyrosine kinase binding protein to transduce activating signals. KIR proteins are thought to play an important role in regulation of the immune response. Functionally, KIR2DL5A and KIR2DL5B are receptors on natural killer (NK) cells for HLA-C alleles and prevent cell lysis by inhibiting the activity of NK cells.
仅用于科研。不用于诊断过程。未经明确授权不得转售。
篇参考文献 (0)
生物信息学
蛋白别名: CD158; KIR2DL; NKAT; NKAT1